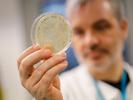

Joe Palca appears in the following:
Where Vaccines To Prevent COVID-19 Stand
Thursday, April 02, 2020
More than two dozen vaccines for COVID-19 are underdevelopment, and at least three have begun human tests. Here's what's being tried, and why it's now possible to develop candidates in record time.
An Update On The Drugs Being Developed And Tested To Fight COVID-19
Tuesday, March 31, 2020
Lots of drugs are being tried to combat COVID-19, but only a handful are being tested in a scientific manner. Here's a look at what's being studied, and what possible therapies lie ahead.
Clinical Trials Set To Determine If Anti-Malaria Drug Effective Against COVID-19
Tuesday, March 31, 2020
At least one team of scientists hopes to determine if hydroxychloroquine — touted by President Trump as a possible treatment for COVID-19 — could actually work to prevent the disease.
How Monoclonal Antibodies Might Prove Useful Against The Coronavirus
Thursday, March 26, 2020
A treatment strategy that identifies particularly potent immune system proteins, then gins up mass quantities for a single dose might help prevent infections or quell symptoms, scientists say.
Behind The Race To Develop Antibody-Based Treatments For COVID-19
Thursday, March 26, 2020
Several teams are racing to develop therapies for COVID-19 based on antibodies, the components of immune systems that can be collected from the blood of patients who have survived the disease.
FDA Expedites Treatment Of Seriously Ill COVID-19 Patients With Experimental Plasma
Tuesday, March 24, 2020
Scientists are rolling out an old-fashioned approach they hope will help treat COVID-19. The treatment involves giving patients plasma from people who have recovered from the virus.
Supercomputers Recruited To Hunt For Clues To A COVID-19 Treatment
Tuesday, March 24, 2020
Scientists hope a machine can do what a person can't: quickly analyze every physical and chemical aspect of the coronavirus and sift through the world's drugs for subtle clues that might prove useful.
Increase In Availability Of Coronavirus Tests
Saturday, March 21, 2020
The Trump administration suggested that widespread testing is underway but that the country is only in day six of the 15-day plan to slow the spread of the coronavirus.
U.S. Flu Season Beginning To Ease, Modelers Say
Monday, March 09, 2020
Though COVID-19 has captured the headlines, influenza places a huge burden on the health care system. This year's flu shot provides good protection, the CDC says, so do get one if you haven't already.
Coronavirus: Italy Travel Restrictions
Sunday, March 08, 2020
More than 100,000 people around the world have been diagnosed with the illness COVID-19. A number of governments are now trying to contain the spread of the virus.
Respirators Key To Coronavirus Battle But They Must Be Worn Correctly
Friday, March 06, 2020
A respirator is a central piece of protective gear vital for keeping health care workers healthy — but wearing one incorrectly can put the wearer at risk.
Hunt For New Coronavirus Treatments Includes Gene-Silencing And Monoclonal Antibodies
Wednesday, February 19, 2020
The new coronavirus has spurred biotech labs in universities and companies to try to find new approaches to stopping the virus — from blocking its key enzymes to interfering with its genetics.
In The Fight Against COVID-19, Labs Look To Create Coronavirus Antibodies
Tuesday, February 18, 2020
An approach to treating new diseases that worked for the Ebola and Zika viruses is being tested for the new coronavirus. It involves using antibodies to the disease as a drug.
DARPA Aims To Have Coronavirus Vaccine Shortly After Outbreak's Start
Friday, February 14, 2020
The Defense Advanced Research Projects Agency supports a pandemic preparedness program that is designed to respond rapidly to an emerging threat such as the coronavirus.
Timetable For A Vaccine Against The New Coronavirus? Maybe This Fall
Wednesday, February 12, 2020
Recent advances in biotech make scientists optimistic that they might have a vaccine that has passed basic tests of human safety and efficacy ready to go to clinics as soon as this fall.
The U.S. Government Is Sharing Its Test For The New Coronavirus
Wednesday, February 05, 2020
Right now, the CDC in Atlanta is the only place that can definitively test for the new coronavirus. But soon regional public health labs will get in the game, and kits are being developed for doctors.
The State Of A Potential Vaccine For The New Coronavirus
Wednesday, January 29, 2020
Several teams are working on a vaccine to protect against the new coronavirus. Although a vaccine is many months off, new technologies have helped build potential vaccines in record time.
A Travel Ban To Contain The Coronavirus Could Worsen Conditions In Wuhan
Saturday, January 25, 2020
China is enforcing travel restrictions on several cities, affecting millions of people. But research shows that these measures are not effective. In fact, they might make the situation even worse.
NASA Will Try Out An Instrument Designed To Make Oxygen On Mars
Wednesday, January 01, 2020
The next Mars mission will have an instrument that can make oxygen from the carbon dioxide in the Martian atmosphere. It will be crucial for keeping astronauts alive and for fueling rockets.
Electrical Field May Speed Wound Healing By Encouraging Cell Regeneration
Monday, December 30, 2019
A scientist in Wisconsin has invented a bandage that uses an electrical field to speed up the time needed for a wound to heal. It could one day lead to treatments for baldness and obesity.